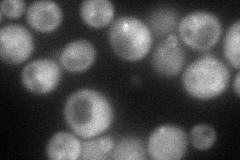
YGR261C
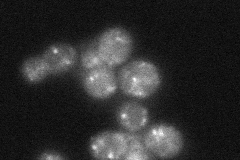
YGR261C
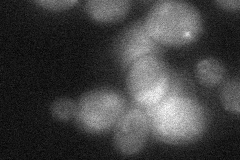
YGR261C
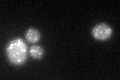
YGR261C

View description
Beta3-like subunit of the yeast AP-3 complex; functions in transport of alkaline phosphatase to the vacuole via the alternate pathway; exists in both cytosolic and peripherally associated membrane-bound pools
Localization:
Intensity:
Fold change:
Significance:
-
C’ GFP library in SD

punctate37.49 -
N' NOP1pr-GFP in SD
cytosol,punctate89.1206 -
N' TEF2pr-mCherry in SD

cytosol,punctate75.3712 -
N' NATIVEpr-GFP in SD
punctate33.2417 -
N' TEF2pr-VC and Cyto-VN in SD
cytosol28.926 -
C’ GFP library in SD+DTT
punctate31.270.83No -
C’ GFP library in SD+H2O2

punctate39.651.05No -
C’ GFP library in Starvation Media

punctate36.370.96No -
C’ GFP library on the background of Pup2-DaMP

punctate -
C’ GFP library on the background of CCT mutant

punctate29.90320.797343No
